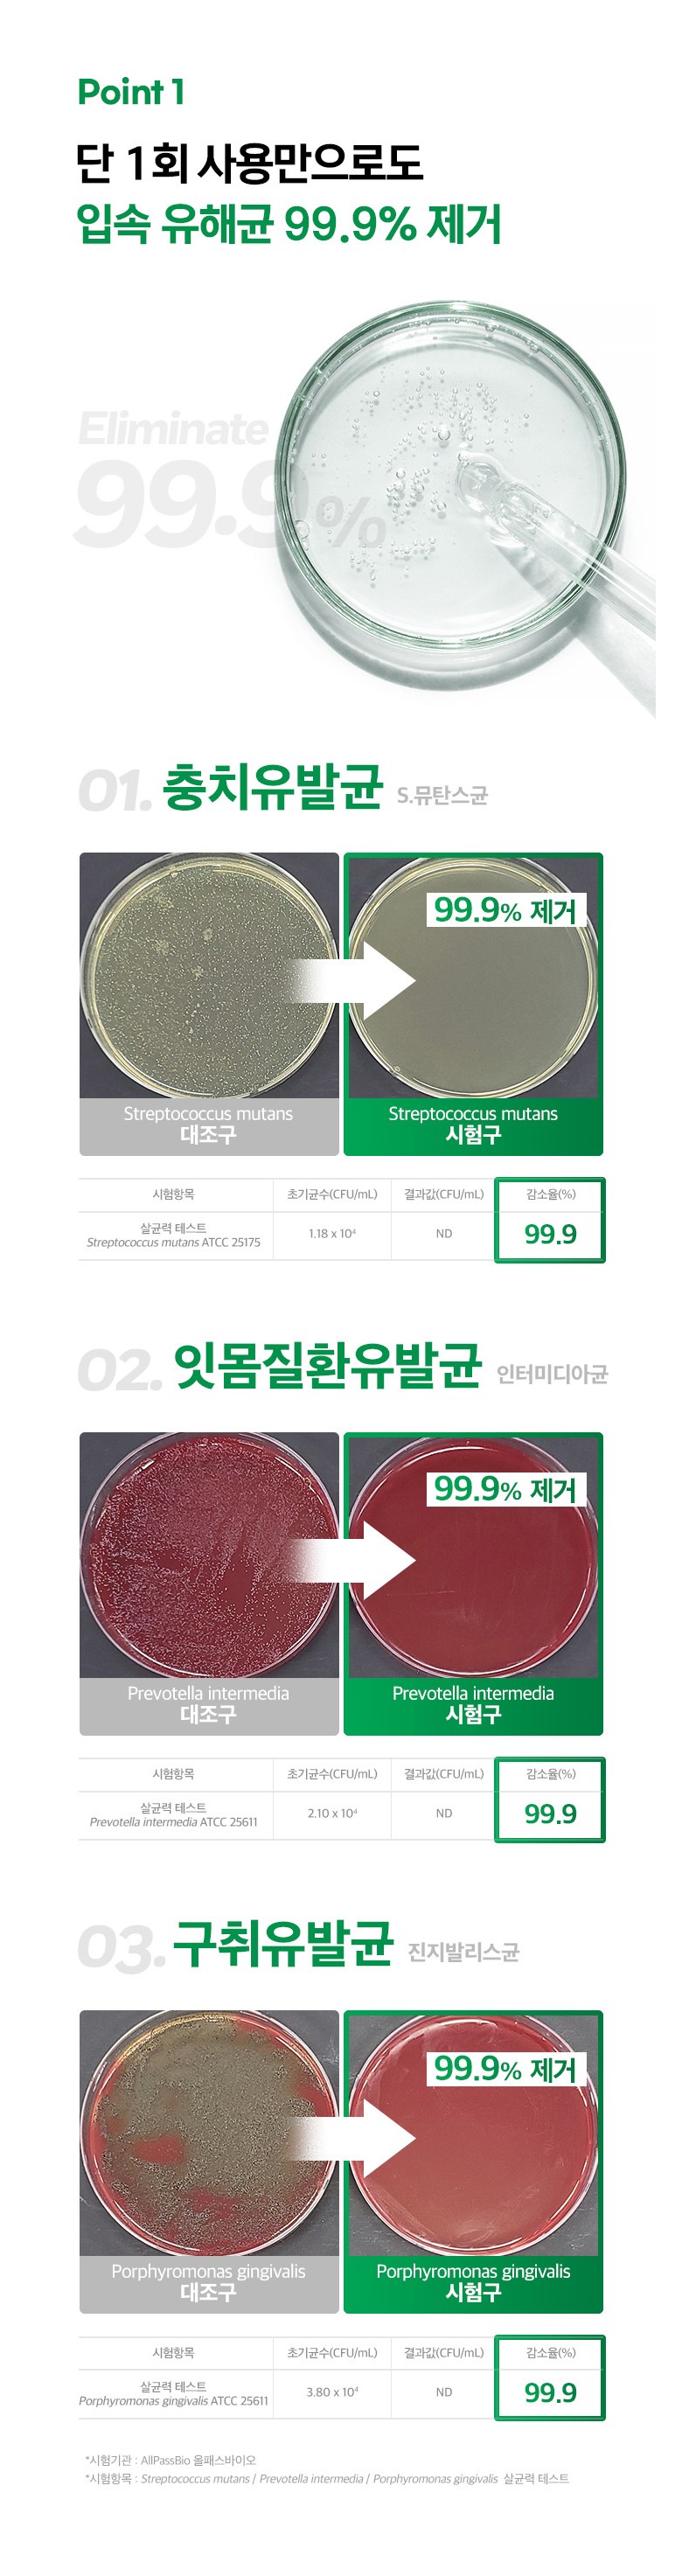

최근본상품

68%
71,710원
22,900원
(10g당 382원)


수량
모든 옵션 보기
이 상품은 내일 도착, 무료배송
내일(수) 3/18 도착 보장 (11시간 40분 내 주문 시 / 서울⋅경기 기준)
판매자:주식회사 하이퍼플로우
적립
최대 1,145원· 쿠페이 머니 결제시
혜택보기
PC에서도 간편한 결제 쿠페이머니
쿠페이머니 카드
카드 계좌이체
계좌이체
 쿠페이머니
쿠페이머니 카드
카드 계좌이체
계좌이체- 유통기한: 2028-03-10 이거나 그 이후인 상품
- 용기형태: 튜브형
- 기능: 잇몸케어
- 사용대상: 일반/성인
- 무설탕여부: 무설탕
- 쿠팡상품번호: 8673627573 - 25178879207
필수 표기 정보
| 품명 및 모델명 | 상품 상세페이지 참조 | 인증/허가 사항 | 상품 상세페이지 참조 |
| 제조국(원산지) | 상품 상세페이지 참조 | 제조자(수입자) | 상품 상세페이지 참조 |
| 소비자상담 관련 전화번호 | 상품 상세페이지 참조 | ||
필수 표기 정보 더보기더보기
판매자가 현금거래를 요구하면 거부하시고 즉시 사기 거래 신고센터 (1670-9832)에 신고하시기 바랍니다.

상품 리뷰
동일한 상품에 대해 작성된 상품 리뷰로, 판매자는 다를 수 있습니다.
동일한 상품에 대해 작성된 상품 리뷰로, 판매자는 다를 수 있습니다.
등록된 상품평이 없습니다.
상품문의
- 구매한 상품의 취소/반품은 마이쿠팡 구매내역에서 신청 가능합니다.
- 상품문의 및 후기게시판을 통해 취소나 환불, 반품 등은 처리되지 않습니다.
- 가격, 판매자, 교환/환불 및 배송 등 해당 상품 자체와 관련 없는 문의는 고객센터 내 1:1 문의하기를 이용해주세요.
- "해당 상품 자체"와 관계없는 글, 양도, 광고성, 욕설, 비방, 도배 등의 글은 예고 없이 이동, 노출제한, 삭제 등의 조치가 취해질 수 있습니다.
- 공개 게시판이므로 전화번호, 메일 주소 등 고객님의 소중한 개인정보는 절대 남기지 말아주세요.
아직 문의가 없습니다.
판매 부적격 상품 또는 허위과장광고 및 지식재산권을 침해하는 상품의 경우 신고하여 주시기 바랍니다.
배송정보
| 배송방법 | 순차배송 | 배송비 | 무료배송 - 로켓배송 상품 중 19,800원 이상 구매 시 무료배송 - 도서산간 지역 추가비용 없음 |
|---|---|---|---|
| 묶음배송 여부 | 가능 | ||
| 배송기간 |
| ||
교환/반품 안내
- ㆍ교환/반품에 관한 일반적인 사항은 판매자가 제시사항보다 관계법령이 우선합니다.
다만, 판매자의 제시사항이 관계법령보다 소비자에게 유리한 경우에는 판매자 제시사항이 적용됩니다.
| 교환/반품 비용 | ㆍ와우멤버십 회원: 무료로 반품/교환 가능 ㆍ와우멤버십 회원 아닌 경우: 1) [총 주문금액] - [반품 상품금액] = 19,800원 미만인 경우 반품비 5,000원 2) [총 주문금액] - [반품 상품금액] = 19,800원 이상인 경우 반품비 2,500원 |
|---|---|
| 교환/반품 신청 기준일 | ㆍ단순변심에 의한 로켓배송 상품의 교환/반품은 제품 수령 후 30일 이내까지, 교환/반품 제한사항에 해당하지 않는 경우에만 가능 (교환/반품 비용 고객부담) ㆍ상품의 내용이 표시·광고의 내용과 다른 경우에는 상품을 수령한 날부터 3개월 이내, 그 사실을 안 날 또는 알 수 있었던 날부터 |
교환/반품 제한사항
- ㆍ주문/제작 상품의 경우, 상품의 제작이 이미 진행된 경우
- ㆍ상품 포장을 개봉하여 사용 또는 설치 완료되어 상품의 가치가 훼손된 경우 (단, 내용 확인을 위한 포장 개봉의 경우는 예외)
- ㆍ고객의 사용, 시간경과, 일부 소비에 의하여 상품의 가치가 현저히 감소한 경우
- ㆍ세트상품 일부 사용, 구성품을 분실하였거나 취급 부주의로 인한 파손/고장/오염으로 재판매 불가한 경우
- ㆍ모니터 해상도의 차이로 인해 색상이나 이미지가 실제와 달라, 고객이 단순 변심으로 교환/반품을 무료로 요청하는 경우
- ㆍ제조사의 사정 (신모델 출시 등) 및 부품 가격 변동 등에 의해 무료 교환/반품으로 요청하는 경우
※ 각 상품별로 아래와 같은 사유로 취소/반품이 제한될 수 있습니다.
| 의류/잡화/수입명품 | ⋅ 상품의 택(TAG) 및 라벨의 멸실 또는 훼손, 상품의 사용 또는 훼손, 구성품 누락으로 상품의 가치가 현저히 감소된 경우 |
|---|---|
| 계절상품/식품/화장품 | ㆍ신선/냉장/냉동 상품의 단순변심의 경우 ㆍ뷰티 상품 이용 시 트러블(알러지, 붉은 반점, 가려움, 따가움)이 발생하는 경우, |
| 전자/가전/설치상품 | ㆍ설치 또는 사용하여 재판매가 어려운 경우 ㆍ상품의 시리얼 넘버 유출로 내장된 소프트웨어의 가치가 감소한 경우 (내비게이션, OS시리얼이 적힌 PMP) ㆍ홀로그램 등을 분리, 분실, 훼손하여 상품의 가치가 현저히 감소하여 재판매가 불가할 경우 (노트북, 데스크탑 PC 등) |
| 자동차용품 | ㆍ상품을 개봉하여 장착한 이후 단순변심인 경우 |
| CD/DVD/GAME/ BOOK | ㆍ복제가 가능한 상품의 포장 등을 훼손한 경우 |
판매자 정보
| 소비자상담 및 교환반품 문의 | 쿠팡고객센터 1577-7011 배송 및 환불/교환에 대한 문의는 마이쿠팡-고객센터 내 상담하기를 이용해주세요. | ||
|---|---|---|---|
상호/대표자 | 주식회사 하이퍼플로우 / 이종운 | 사업장 소재지 | 경기도 안양시 동안구 엘에스로116번길 118 904호 |
e-mail | bbaner@naver.com | 연락처 | 010-8212-4051 |
통신판매업 신고번호 | 제2022-안양동안-8093호 | 사업자번호 | 794-86-02581 |
구매안전 서비스 | 02-006-00042 서비스 가입사실 확인 > 본 판매자는 고객님의 안전거래를 위해 관련 법률에 의거하여 쿠팡페이의 구매안전서비스를 적용하고 있습니다. | ||
미성년자가 체결한 계약은 법정대리인이 동의하지 않는 경우 본인 또는 법정대리인이 취소할 수 있습니다. 쿠팡은 통신판매중개자로서 통신판매의 당사자가 아니며, 광고, 고시정보, 상품 주문, 배송 및 환불의 의무와 책임은 각 판매자에 있습니다.








